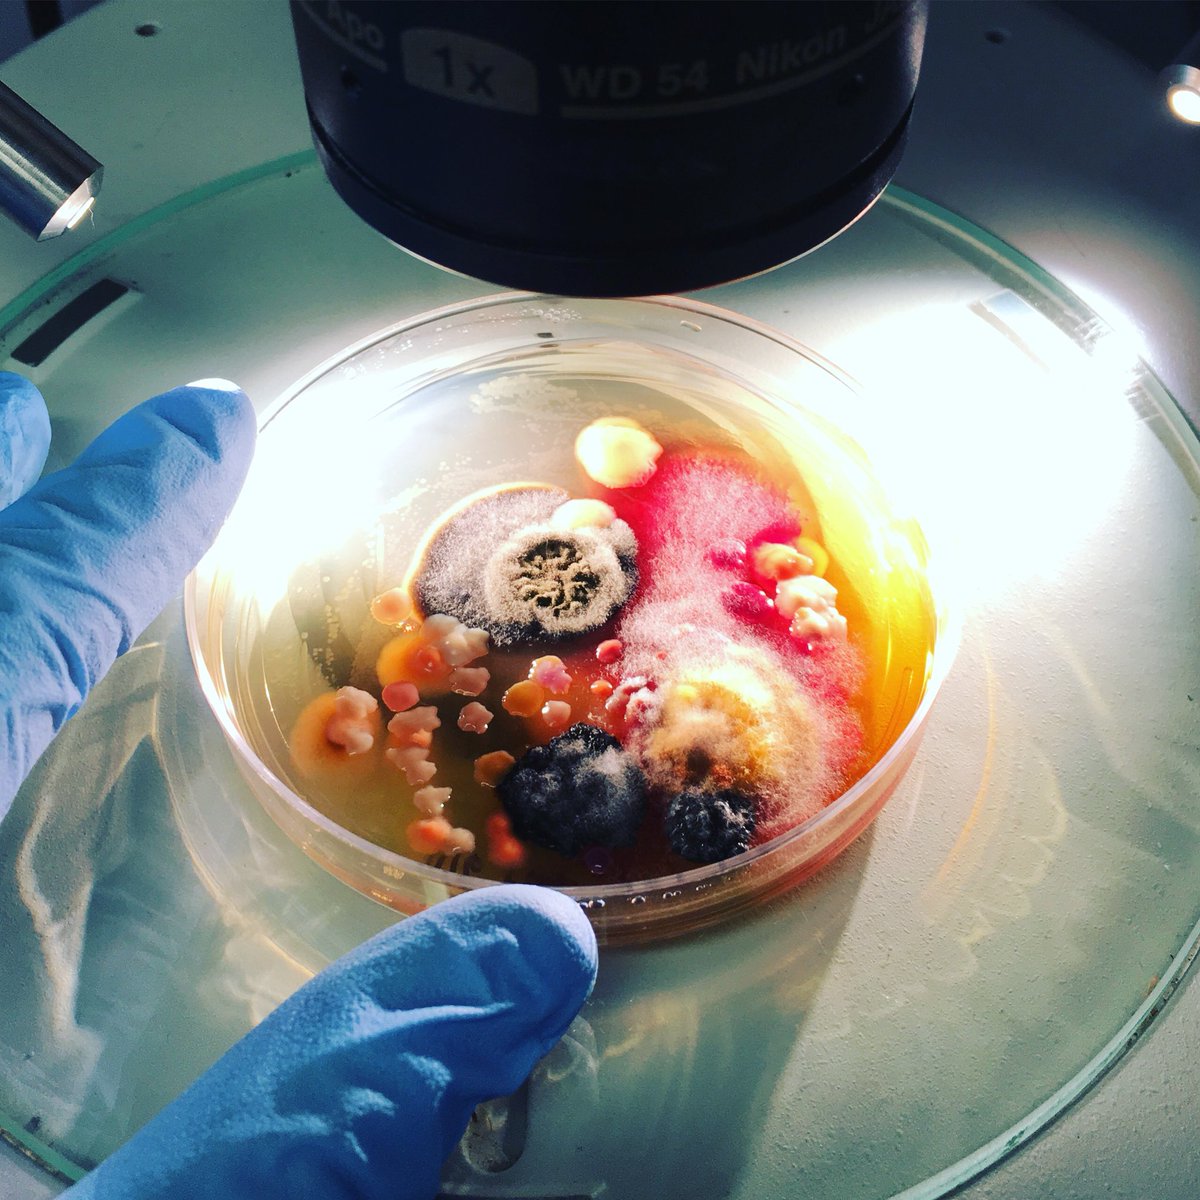
Dr. Anne A Madden tweet media
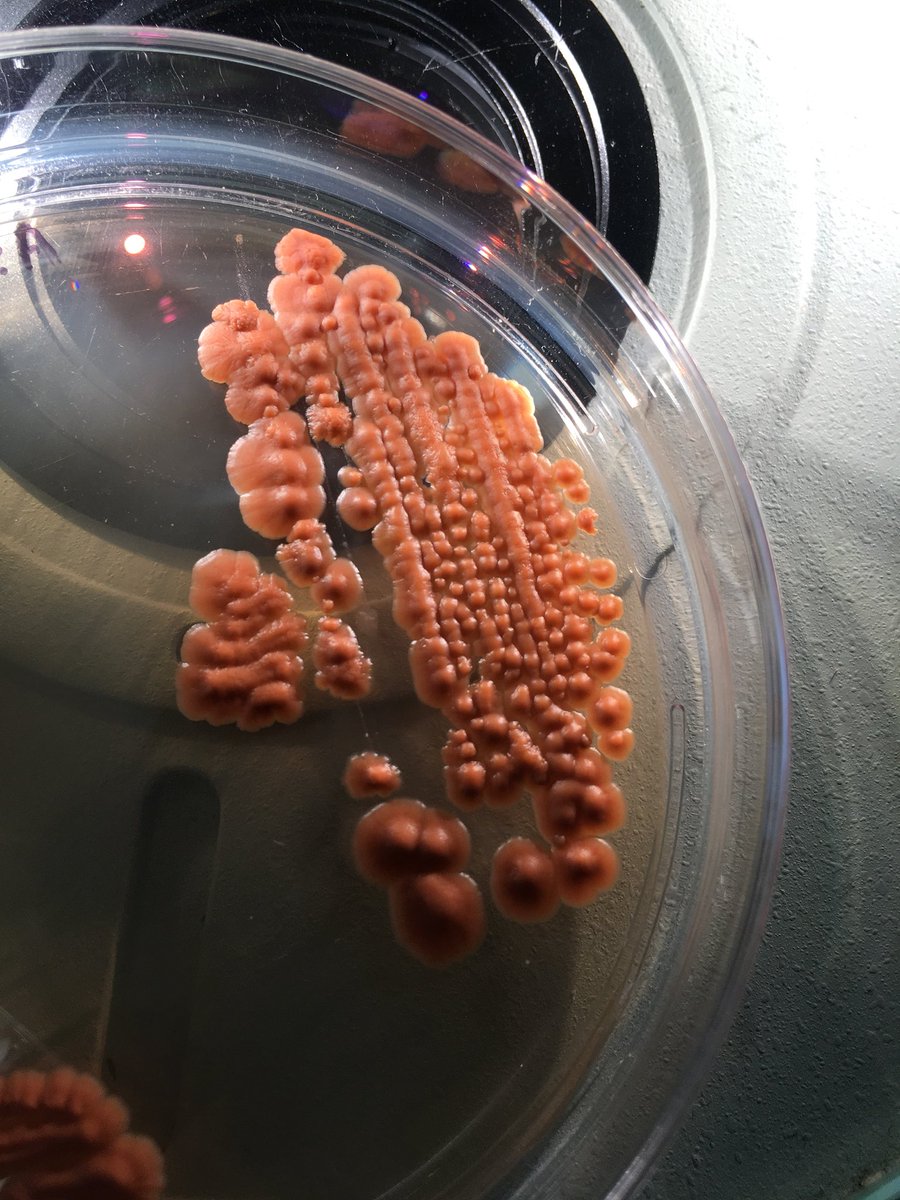
Dr. Anne A Madden tweet media

Maureen Hillenmeyer retweetledi

Great slide (Bluestar Advisors) about progress across different cancers.
They looked at OS improvement in 1st line patients and divided indications to blue ocean or red ocean based on magnitude of improvement.
Biggest progress was in melanoma and renal cancer (PD1/CTLA4), HRD-ovarian cancer (PARP) and breast cancer (CDK4, HER2).
Good news is a lot of the blue ocean indications at the bottom will see new effective therapies that should translate to a meaningful benefit when they reach 1st line:
💢Head and neck - EGFR bispecifics (peto, amivantamab)
💢Small cell lung cancer - DLL3 T cell engagers and Topo1 ADCS (DLL3, SEZ6, B7H3)
💢Ovarian/ endometrial - Topo1 ADCs (FRa, CDH6, NaPi2b)
💢Pancreatic - RAS inhibitors
GBM, colorectal and liver still look very challenging...

English